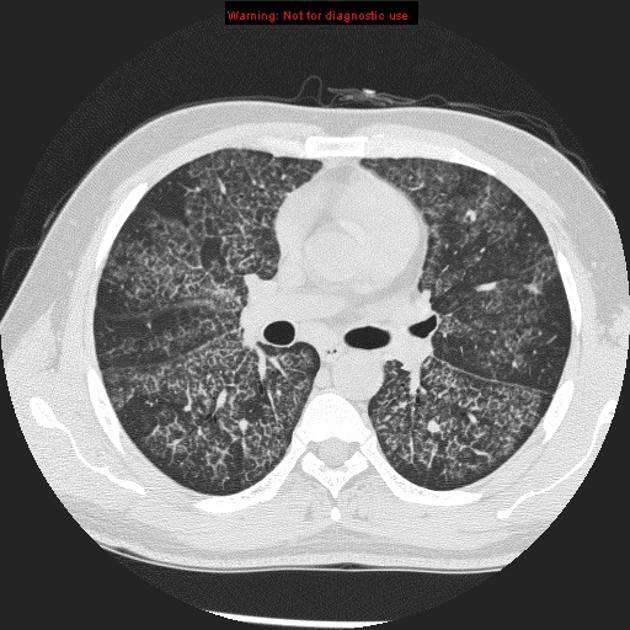
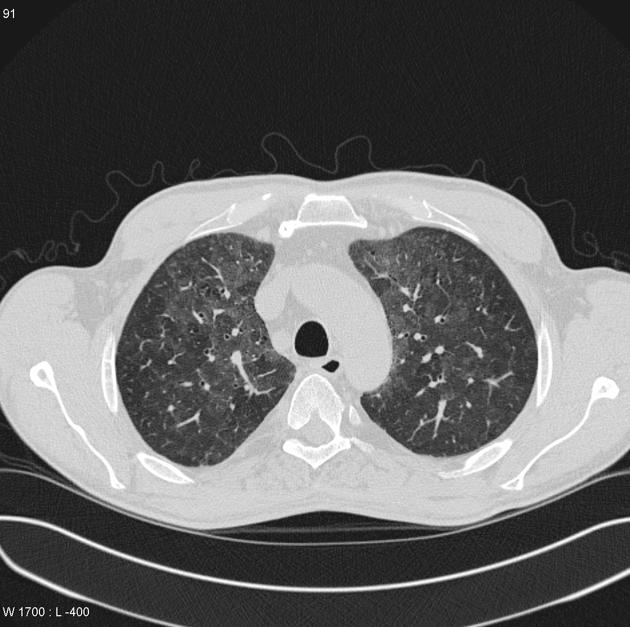

When is pancoast’s tumour unresectable? (4)
What type of lung cancer?

Non small cell lung cancer (Squamous cell)
Name the different types of pathology with thymus (4)
What are the associations with thymoma? (3)
Name the anterior mediastinal masses: (4)
Most common teratoma in anterior mediastinum:
Germ cell tumour
What is the appearance of teratoma?
Cystic mass + fat +/- calcification ?teeth
What is the most common location for pericardial cyst?
Right anterior cardiophrenic angle.

Name the posterior mediastinal masses: (2 and then 7)
a) Neurogenic: -
b) BM -
Name the middle mediastinal masses: (4)
What are the causes of lipoid pneumonia?

a) Exogenous- aspiration of oil
b) Endogenous- more common- secondary to post obstructive processes ie Fat density in consolidation

Re Pulmonary alveolar proteinosis-PAP
a) What are they at increased risk?
b) Appearances?
c) Treatment?
a) increased risk of Nocardia infection- brain abscess
b) Crazy paving with septal thickening and GGO
c) Bronchoalveolar lavage
What are the three stages of congestive cardiac failure?
What are the DDx for crazy paving? (5) ie septal thickening and GG
What differentiates a benign from malignant nodule? (3)
Malignant:
Benign:
Re Squamous cell lung cancer:
What type is a pancoast tumour?
Squamous cell
Re Small cell lung cancer:
Where is large cell lung cancer usually located?
It is usually peripheral.
What is a Lambert Eaton syndrome?
Proximal muscle weakness secondary to ACh near NMJ.
Where is the predominance of NSIP?

Lower lobes, posterior and peripheral predominance with sparring of the immediate subpleural spaces.
immediate subpleural sparing - a relatively specific sign
What causes NSIP? (3)
it is important to carefully scrutinise the images, looking for findings such as joint or bony changes, oesophageal dilatation, pleural and pericardial effusion, etc. as it has been mentioned earlier NSIP pattern is also associated with many other conditions.
What is the histology in UIP?
Heterogenous
List the differences between NSIP and UIP:
NSIP:
UIP:
RB-ILD- Smoking related